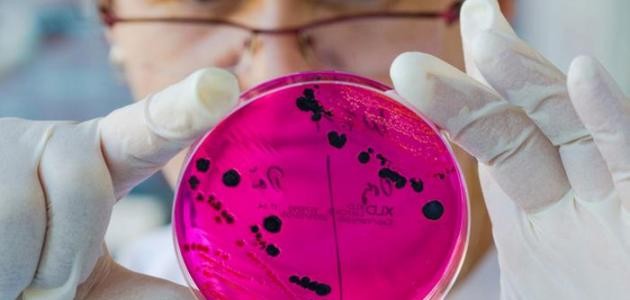
انتشار مرض الزهري

مرض الزهري
يُعدّ الزهري (بالإنجليزيّة: Syphilis) عدوى بكتيريّة، تنتقل عن طريق الاتصال الجنسي، وتُسمّى البكتيريا المُسبّبة للمرض باللولبيّة الشاحبة (بالإنجليزيّة: Treponema pallidum)، ويمكن التعافي من مرض الزهري في حال تمّ علاجه بالمضادّات الحيويّة المناسبة، وخاصّةً خلال المراحل الأولى للمرض، بينما قد يُسبّب مشاكل صحيّة خطيرة، قد تصل إلى حد الموت في حال لم يتمّ علاجه.
كان مرض الزهري يُهدّد الصحّة العامّة في السابق، لما يُسبّبه من مضاعفات ومشاكل صحيّة خطيرة، وذلك حتى اكتشاف المضاد الحيوي البنسلين (بالإنجليزية: Penicillin) في أواخر الأربعينيّات من القرن العشرين، وبناءً على إحصائيّات مراكز مكافحة الأمراض واتقائها (بالإنجليزيّة: Centers for Disease Control and Prevention)، فقد تراجعت معدّلات الإصابة بالمرض خلال الفترة الواقعة بين نهاية القرن العشرين وبداية القرن الواحد والعشرين، ولكن بدأت حالات جديدة بالظهور مجدّداً، ليتضاعف عدد المصابين من 8724 مصاباً إلى 16663 مصاباً، خلال الفترة ما بين عام 2005 وحتى عام 2013، واستمرّت الأعداد بالزيادة حتى وصلت 19999 مصاباً في عام 2014، وتجدر الإشارة إلى أنّ الزهري من الأمراض التي تنتقل عبر الجنس بكافة أشكاله.
أعراض مرض الزهري
تختلف الأعراض لمرض الزهري بحسب مراحله المتتابعة في الغالب، ولكنّها قد تتداخل فيما بينها، كما قد يتأخر ظهور الأعراض لسنوات عدة، ويمكن أن تحدث هذه الأعراض دون ترتيب محدد.
الزهري الأولي
تتميّز هذه المرحلة بظهور قُرح دائريّة صغيرة وغير مُؤلمة، تسمى بالقرح الصلبة (بالإنجليزية: Chancre)، قد تظهر هذه القرح على الفم وداخله، أو في المنطقة التناسليّة، أو على المستقيم؛ وهي الأماكن التي من الممكن للبكتيريا المُسببة للزهري الدخول منها إلى الجسم، وتكون هذه القُرح شديدة العدوى عند ملامستها مباشرة، وفي الحقيقة تظهر هذه القُرح بعد ثلاثة إلى أربعة أسابيع من التعرّض للعدوى في الغالب، ولكنّها قد تظهر في أي وقت خلال عشرة أيّام وحتى تسعين يوماً من العدوى، وتحتاج القُرح لتتعافى مدّة تتراوح بين أسبوعين وحتى ستة أسابيع.
الزهري الثانوي
تظهر أعراض المرحلة الثانية من الزهري خلال أسبوعين إلى 10 أسابيع من الإصابة بالمرض، وتختفي هذه الأعراض من تلقاء نفسها دون علاج،
- طفح جلدي خشن لا يُسبّب الحكّة، يميل لونه للأحمر أو البنيّ المحمر، يظهر على جذع الجسم، وينتشر لباقي الأجزاء، كما يظهر على راحة اليد وباطن القدم.
- قُرح جلديّة تشبه في شكلها الثآليل، تظهر في منطقة التجويف الفموي، أو منطقة الشرج، أو المنطقة التناسليّة.
- آلام في العضلات.
- الحمّى.
- التهاب الحلق.
- انتفاخ العُقد اللمفاويّة.
- تساقط الشعر على شكل خصل كبيرة تاركة رقعاً دائرية على فروة الرأس.
- الصداع.
- فقدان الوزن.
- التعب والإرهاق.
الزهري الكامن
ينتقل المرض إلى مرحلة الزهري الكامن أو المخفي (بالإنجليزيّة: Latent syphilis) في حال لم يتم علاج مرض الزهري خلال المراحل السابقة، وتتميّز المرحلة المخفيّة باستمرارها لعدة أعوام دون المعاناة من أيّ أعراض خلالها، ثم يزداد المرض سوءاً وينتقل إلى المرحلة الأخيرة.
الزهري الثالثي
تظهر مرحلة الزهري الثالثي (بالإنجليزيّة: Tertiary syphilis) وهي المرحلة الأخيرة من الزهري بعد عدّة سنوات أو عدّة عقود من الإصابة الأوليّة بالعدوى، وتُمثّل هذه المرحلة خطراً كبيراً على حياة الفرد؛ إذ قد تُؤدي إلى العديد من المضاعفات الصحيّة، ومنها ما يلي:
- فقدان البصر أو العمى (بالإنجليزية: Blindness).
- الصمم أو ضعف السمع.
- الأمراض العقلية.
- فقدان الذاكرة.
- تلف في أنسجة العظام والأنسجة الرخوة في الجسم.
- الاضطرابات العصبية مثل السكتة الدماغية، والتهاب السحايا.
- مشاكل وأمراض القلب.
- وصول عدوى الزُهري إلى الدماغ أو النخاع الشوكي مُسبّباً ما يُعرف بالزهري العصبي (بالإنجليزيّة: Neurosyphilis).
تشخيص مرض الزهري
لتشخيص المرض يقوم الطبيب بالسؤال عن التاريخ الجنسي للمريض، بالإضافة إلى الفحص البدني، ثم يطلب بعض الفحوصات المخبريّة للتأكد من وجود المرض، وفي حال تشخيص مرض الزهري عند الفرد، يجب إجراء الفحوصات التشخيصيّة للشريك، ومن هذه الفحوصات ما يلي:
- فحص الدم: بسبب بقاء الأجسام المضادّة لمرض الزهري في الدم لسنوات عدّة، يستطيع هذا الفحص الكشف عن الإصابة بالعدوى الحديثة أو القديمة.
- فحص السائل الجسدي: يتم في هذا الفحص اختبار السائل الموجود داخل القُرح الصلبة الظاهرة على جسم المريض، خلال المراحل الأوليّة والثانوية.
- فحص السائل الدماغيّ الشوكيّ: (بالإنجليزيّة: Cerebrospinal fluid) يُطلب فحص السائل الدماغيّ الشوكيّ في بعض الأحيان، للكشف عن وجود العدوى في الجهاز العصبي، وذلك من خلال البزل القطني (بالإنجليزيّة: Spinal tap).
علاج مرض الزهري
يمكن علاج المراحل الأوليّة والثانويّة لمرض الزهري باستخدام حُقنة تحتوي على المضاد الحيوي بنسلين، بينما تُستخدم أنواع أخرى من المضادات الحيوية مثل؛ دوكسيسايكلين (بالإنجليزيّة: Doxycycline)، أو أزيثرومايسين (بالإنجليزيّة: Azithromycin)، أو سيفترياكسون (بالإنجليزيّة: Ceftriaxone) في حال وجود تحسّس تجاه البنسلين، كما تستدعي الإصابة بالزهري العصبي إلى دخول المستشفى لأخذ حُقن يوميّة من البنسلين لإتمام العلاج، ولكن للأسف لا يُمكن إصلاح التلف الحاصل خلال المراحل الأخيرة من المرض، بينما يمكن تخفيف الألم والانزعاج فقط، وتجدر الإشارة إلى ضرورة الامتناع عن ممارسة الجنس حتى إتمام العلاج، والتئام جميع القُرح الجلديّة في جسم المصاب، بالإضافة إلى ضرورة إعطاء العلاج لشريك المصاب.
مرض الزهري والحمل
تؤدي إصابة الحوامل بمرض الزهري إلى مضاعفات عدّة منها؛ ولادة طفل بوزن قليل، أو ولادة مبكرة، أو ولادة طفل ميت، بالإضافة إلى إمكانيّة نقل عدوى الزهري من الأم الحامل إلى جنينها خلال فترة الحمل، لذلك من الأفضل إجراء فحص
مرة واحدة على الأقل خلال الحمل، للتأكد من عدم وجود المرض لدى الحامل، وتلقّي العلاج اللازم في حال الإصابة بمرض الزهري، وذلك لتفادي حدوث مضاعفات خطرة عند الطفل؛ إذ قد يولد الطفل المصاب دون المعاناة من أيّة أعراض لمرض الزهري، وخلال أسابيع قليلة، إذا لم يتلقى الطفل العلاج، تتطوّر الحالة وتسبب مشاكل صحيّة تتمثّل في؛ إعتام عدسة العين (بالإنجليزيّة: Cataracts)، وفقدان السمع، والإصابة بنوبات الصرع، كما قد يتسبّب في موت الطفل.
الوقاية من مرض الزهري
في الحقيقة لا يوجد لقاح خاص للوقاية من مرض الزهري،
- استخدام العازل الذكري، مع التأكد من تغطيته للقُرح الجلديّة إن وُجدت.
- تجنّب تعاطي المؤثرات العقلية؛ حيث إنّ استخدام الكحول والمخدرات قد يؤثر في التحكم بعملية اتخاذ القرارات، مما قد يؤدي لممارسة الجنس غير الآمن.
فيديو انتشار مرض الزهري
هل بسبب أنه مرض معدٍ يزيد من نسبة انتشاره أم ماذا؟ :
المراجع
- 1 - Lori Smith (21-12-2017), " Syphilis: What you need to know " , www.medicalnewstoday.com , 22-4-2018. Edited. .
- 2 - Jennifer Robinson (18-10-2016), " Syphilis " , www.webmd.com , 22-4-2018. Edited. .
- 3 - Mayo Clinic Staff (10-1-2018), " Syphilis " , www.mayoclinic.org , 22-4-2018. Edited. .
- 4 - Shannon Johnson (28-11-2017), " Syphilis " , www.healthline.com , 22-4-2018. Edited. .
- 5 - Syphilis – CDC Fact Sheet , www.cdc.gov , 22-4-2018. Edited. .